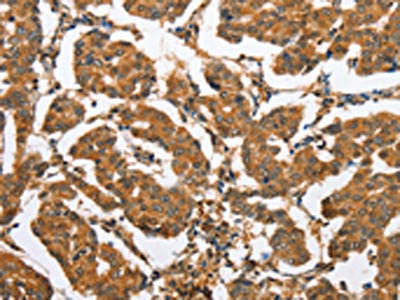

CXCL14 Antibody
-
中文名稱:CXCL14兔多克隆抗體
-
貨號:CSB-PA568771
-
規格:¥1100
-
圖片:
-
The image on the left is immunohistochemistry of paraffin-embedded Human breast cancer tissue using CSB-PA568771(CXCL14 Antibody) at dilution 1/60, on the right is treated with fusion protein. (Original magnification: ×200)
-
The image on the left is immunohistochemistry of paraffin-embedded Human brain tissue using CSB-PA568771(CXCL14 Antibody) at dilution 1/60, on the right is treated with fusion protein. (Original magnification: ×200)
-
-
其他:
產品詳情
-
Uniprot No.:
-
基因名:
-
別名:1110031L23Rik antibody; 1200006I23Rik antibody; AI414372 antibody; BMAC antibody; bolekine antibody; BRAK antibody; Breast and kidney antibody; C-X-C motif chemokine 14 antibody; C-X-C motif chemokine ligand 14 antibody; Chaemokine; CXC motif; ligand 14 antibody; Chemokine (C-X-C motif) ligand 14 antibody; Chemokine BRAK antibody; CXC chemokine in breast and kidney antibody; CXCL14 antibody; CXL14_HUMAN antibody; JSC antibody; Kec antibody; Kidney-expressed chemokine CXC antibody; KS1 antibody; MGC10687 antibody; MGC124510 antibody; MGC90667 antibody; MIP 2 gamma antibody; MIP-2G antibody; MIP2G antibody; MIP2gamma antibody; NJAC antibody; PRO273 antibody; PSEC0212 antibody; Scyb14 antibody; Small Inducible Cytokine B14 antibody; Small inducible cytokine subfamily B (Cys-X-Cys) member 14 (BRAK) antibody; Small Inducible Cytokine subfamily B; member 14 antibody; Small-inducible cytokine B14 antibody; Tumor suppressing chemokine antibody; UNQ240 antibody
-
宿主:Rabbit
-
反應種屬:Human
-
免疫原:Fusion protein of Human CXCL14
-
免疫原種屬:Homo sapiens (Human)
-
標記方式:Non-conjugated
-
抗體亞型:IgG
-
純化方式:Antigen affinity purification
-
濃度:It differs from different batches. Please contact us to confirm it.
-
保存緩沖液:-20°C, pH7.4 PBS, 0.05% NaN3, 40% Glycerol
-
產品提供形式:Liquid
-
應用范圍:ELISA,IHC
-
推薦稀釋比:
Application Recommended Dilution ELISA 1:2000-1:5000 IHC 1:50-1:200 -
Protocols:
-
儲存條件:Upon receipt, store at -20°C or -80°C. Avoid repeated freeze.
-
貨期:Basically, we can dispatch the products out in 1-3 working days after receiving your orders. Delivery time maybe differs from different purchasing way or location, please kindly consult your local distributors for specific delivery time.
-
用途:For Research Use Only. Not for use in diagnostic or therapeutic procedures.
相關產品
靶點詳情
-
功能:Potent chemoattractant for neutrophils, and weaker for dendritic cells. Not chemotactic for T-cells, B-cells, monocytes, natural killer cells or granulocytes. Does not inhibit proliferation of myeloid progenitors in colony formation assays.
-
基因功能參考文獻:
- These findings indicate that CXCL14 is a critical immunomodulator involved in the stroke-induced inflammatory reaction. PMID: 28382159
- High CXCL14 expression is associated with metastatic progression of Ovarian Cancer. PMID: 28087599
- These results suggest that CXCL14 downregulation by human papillomaviruses plays an important role in suppression of antitumor immune responses. PMID: 27143385
- Platelets are a relevant source of CXCL14. Platelet-derived CXCL14 at the site of vascular lesions might play an important role in vascular repair/regeneration. PMID: 28359053
- Epithelial CXCL14 expression is significantly associated with ERalpha positivity and low proliferation, whereas stromal CXCL14 expression is not linked to any of the established clinicopathological parameters, subtypes of breast cancer or tumour stroma abundance. PMID: 27115465
- Elevated expression of CXCL14 in osteosarcoma tissues correlated with poor prognosis of the osteosarcoma patients. PMID: 27259322
- Elevated S100A6 enhances tumorigenesis and suppresses CXCL14-induced apoptosis in clear cell renal cell carcinoma. PMID: 25760073
- three of these five genes (CXCL14, ITGAX, and LPCAT2) harbored polymorphisms associated with aggressive disease development in a human GWAS cohort consisting of 1,172 prostate cancer patients. PMID: 25411967
- Prometastatic effects of IRX1 were mediated by upregulation of CXCL14/NF-kappaB signaling. PMID: 25822025
- CXCL14 overexpression influences proliferation and changes in cell cycle distributions of HT29 colorectal carcinoma cells. PMID: 24938992
- Data indicate that site-specific CpG methylation in the CXC chemokine CXCL14 promoter is associated with altered expression. PMID: 25102097
- CXCL14 displays antimicrobial activity against E. coli and S. aureus. PMID: 12949249
- Genetic or pharmacologic inhibition of NOS1 reduced the growth of CXCL14-expressing fibroblasts. PMID: 24710408
- CXCL14 inhibits colorectal cancer migration, invasion, and epithelial-to-mesenchymal transition (EMT) by suppressing NF-kappaB signaling. PMID: 24099668
- Downregulation of CXCL14 expression is associated with gastric adenocarcinoma. PMID: 23982764
- CXCL14 plays a pivotal role as a potential tumor suppressor in hepatocellular carcinoma. PMID: 24033560
- Smoking-induced CXCL14 expression in the human airway epithelium links chronic obstructive pulmonary disease to lung cancer. PMID: 23597004
- CXCL14 binding to glycoproteins harboring heparan sulfate proteoglycans and sialic acids leads proliferation and migration of some cancer cells. PMID: 23161284
- CXCL14 might be a potential novel prognostic factor to predict the disease recurrence and overall survival and could be a potential target of postoperative adjuvant therapy in CRC patients PMID: 23294544
- CXCL14 is a negative regulator of growth and metastasis in breast cancer. PMID: 22910931
- These results indicated that upregulation of BRAK was accompanied by differentiation of epithelial cells induced by calcium/calmodulin signaling, and that SP1 binding to the BRAK promoter region played an important role in this signaling. PMID: 22382027
- The rs2237062 polymorphism in the CXCL14 gene might influence Hepatits B Virus-related hepatocellular carcinoma progression in a Chinese population. PMID: 21556757
- CEACAM-1 and CXCL-14 are involved in the occurrence and development of infantile hemangioma. PMID: 20737948
- The results indicate that oxidative stress induced by H(2)O(2) or HO(*) stimulates angiogenesis and tumuor progression by altering the gene expression of CXCL14 via the EGFR/MEK/ERK pathway in human HNSCC cells. PMID: 20815772
- Data indicate that the expression of BRAK stimulated the formation of elongated focal adhesions of the HSC-3 cells in an autocrine or paracrine fashion, in which stimulation may be responsible for the reduced migration of the cells. PMID: 20067447
- CXCL14 methylation in sputum from asymptomatic early-stage lung cancer cases was associated with a 2.9-fold elevated risk for this disease compared with controls, substantiating its potential as a biomarker for early detection of lung cancer PMID: 20562917
- Taken together, the data indicate that the respective stress-dependent action of p38 isoforms is responsible for the up-regulation of the gene expression of the chemokine BRAK/CXCL14. PMID: 20478268
- CXCL14 removal from conditioned media abolished its chemotactic properties. Findings offer direct evidence for epigenetic regulation of chemokine expression in tumor cells. PMID: 20460540
- Increased severity of collagen-induced arthritis in CXCL14-transgenic mice is associated with enhanced T helper (Th) type 1 cytokine production, elevated autoantibody levels and increased inflammatory cell infiltration into the joints. PMID: 20212097
- Data conclude that CXCL14 is likely to be regulated by progesterone in human endometrium and that it may exert a chemoattractive effect on uNK cells and in part be responsible for their clustering around the epithelial glands. PMID: 19903701
- Results suggest that CXCL14 plays an important role in regulating trophoblast invasion through an autocrine/paracrine manner during early pregnancy. PMID: 19833716
- loss of BRAK expression from tumors may facilitate neovascularization and possibly contributes to immunologic escape PMID: 15548693
- The finding that CXCL14 expression inhibits prostate tumor growth suggests this gene has tumor suppressive functions. PMID: 15651028
- CXCL14 is a potent chemoattractant and activator of dendritic cells (DC) and may be involved in DC homing in vivo. PMID: 15843547
- results indicate that BRAK/CXCL14 is a chemokine, having suppressive activity toward tumor progression of oral carcinoma in vivo PMID: 16884687
- This study elucidates a post-translational mechanism for the loss of CXCL14 in cancer and a novel mode of chemokine regulation. PMID: 16987528
- CXCL14 might play a pivotal role in the pathobiology of pancreatic cancer, probably by regulating cancer invasion. PMID: 18054154
- CXCL14 is a gene target of RhoBTB2 and supports downregulation of CXCL14 as a functional outcome of RhoBTB2 loss in cancer. PMID: 18762809
- CXCL14-positive epithelial cells were found in all tissue types. The expression of CXCL14 was not associated with any tumor or patient characteristics analyzed PMID: 18765527
- Data suggest that despite the structural homology and similarity in tissue distribution of human and murine CXCL14, distinct differences point to diverse, species-specific needs for CXCL14 in epithelial immunity. PMID: 18809336
- Cell supernatant-derived CXCL14 fights bacteria at the earliest stage of infection, well before the establishment of inflammation, and thus fulfills a unique role in antimicrobial immunity. PMID: 19109182
- regulates energy metabolism and eating behaviior, induces insulin resistance, suppresses induction of neovascularization. (review) PMID: 19172796
- identify CXCL14 as a novel autocrine stimulator of fibroblast growth and migration, with multi-modal tumor-stimulatory activities PMID: 19218429
- CXCL14 expression is upregulated by ROS through the AP-1 signaling pathway and promotes cell motility through elevation of cytosolic Ca(2+) by binding to the inositol 1,4,5-trisphosphate receptor on the endoplasmic reticulum in breast cancer. PMID: 19276362
- -A-induced migration depends on the selective and polarized release of 2 chemokines, namely CXC chemokine ligands 12 and 14 PMID: 19339694
顯示更多
收起更多
-
亞細胞定位:Secreted.
-
蛋白家族:Intercrine alpha (chemokine CxC) family
-
組織特異性:Expressed in heart, brain, placenta, lung, liver, skeletal muscle, kidney and pancreas. Highly expressed in normal tissue without inflammatory stimuli and infrequently expressed in cancer cell lines. Weakly expressed in monocyte-derived dendritic cells. N
-
數據庫鏈接:
Most popular with customers
-
-
YWHAB Recombinant Monoclonal Antibody
Applications: ELISA, WB, IHC, IF, FC
Species Reactivity: Human, Mouse, Rat
-
Phospho-YAP1 (S127) Recombinant Monoclonal Antibody
Applications: ELISA, WB, IHC
Species Reactivity: Human
-
-
-
-
-